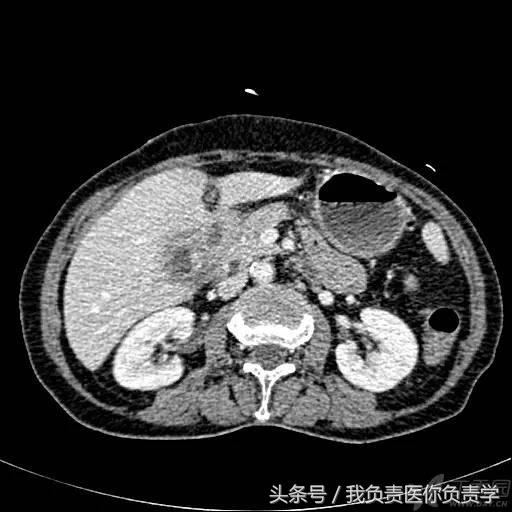
楂樻墜杩涢樁鑵拌吂璁粌,鑳嗗泭缁撶煶绌垮瓟鐥囩姸

前言
胆囊穿孔是急性胆囊炎的严重并发症之一,亦是外科急腹症之一,治疗成败的关键在于能否早期及时的做出正确诊断,而超声检查可为胆囊穿孔的早期诊断提供重要依据。
病因及临床表现
胆囊穿孔主要是由于急性坏疽性胆囊炎所致,其他原因如外伤或医源性损伤不在本文讨论范围。
约10 %的急性胆囊炎患者可发生胆囊穿孔,其中以老年男性患者更为多见,若同时合并有糖尿病或心血管病者更甚。
胆囊穿孔最常发生于胆囊底部,颈部次之。导致胆囊穿孔的发病原因主要是由于各种梗阻性原因(最常为胆囊结石)造成胆囊/胆道堵塞,使得胆囊内压力增高,胆囊壁缺血坏死 ,从而引发穿孔 。
临床上,胆囊穿孔最突出特征为右上腹疼痛,同时可伴有典型的腹膜刺激征,包括腹肌紧张、压痛、反跳痛。患者可表现有发热或黄疸,病情严重者可出现休克体征。
超声表现
根据病程长短不同,胆囊穿孔后可形成 3 种结局,从而导致不同的超声表现:
①急性/亚急性穿孔:此类型的穿孔可因胆汁外漏于腹腔而导致胆汁性腹膜炎。
超声检查可见胆囊壁增厚,形态多饱满增大,也可缩小,大部分病例胆囊内可见结石或絮状沉积物回声,胆囊周围和/或腹腔内可见游离性积液。
典型病例可视察到胆囊壁连续性中断,从而可确定穿孔部位,部分病例可见胆囊内外的无回声经中断的穿孔处随呼吸而相互流动,CDFI检查偶可见因之而产生的彩色多普勒信号。然而,并非所有的穿孔都可以显示胆囊壁的回声中断,有文献报道仅占 61%。
②慢性穿孔:此类型的穿孔可因脓性胆汁外漏并肿物组织包绕形成胆囊周围脓肿,若穿孔处位于肝床侧时可累及肝脏形成肝脓肿。
超声上除部分急性穿孔时的声像图特征外,胆囊周围可见局限性不规则无回声。累及肝脏时,与胆囊相邻的肝脏内也可见不规则低回声区。若病程持续,炎症可累及周围组织器官,可形成腹壁瘘或腹腔内瘘,若瘘管与肠管相通,胆囊内可表现气体回声。
超声诊断胆囊穿孔时应关注以下几点:
1. 并非所有的病例都可发现穿孔的直接证据:若患者临床表现典型,同时胆囊周围或腹腔内探及局限性或游离性积液时,需考虑胆囊穿孔的可能。
2. 由于老年患者反应不敏感,症状可能会与病情不相符,临床表现轻微甚至无明显异常表现,因此针对老年患者在超声检查时不要因为症状不符而轻易排除穿孔的诊断。
典型病例 1
患者男,64岁,因右上腹疼痛半月余就诊。查体发现右上腹部轻压痛,无发热。超声检查所见如下:

图1示胆囊增大,囊壁增厚,囊内透声差

图2示于胆囊外侧可见一局限性囊性无回声区

图3示胆囊与囊性回声区间隐约可见裂隙相通


图4和5为局部放大图像,可见胆囊与囊性回声区间可见直径约2mm的通道
超声检查考虑为胆囊炎合并胆囊穿孔,后经CT检查证实。
典型病例 2
(由丁香园注册用户「chengxiuyan_123」提供)
患者女,68岁,因上腹部痛 8天就诊 。超声检查发现胆囊体积明显增大,内部透声差,囊壁明显增厚,胆囊周围可见不规则分布的液性暗区。胆囊壁局部回声中断,探头加压及松开时,CDFI可见中断处出现因液体进出胆囊而导致的多普勒信号。患者行胆囊切除术,术后证实为胆囊穿孔。

图1示胆囊体积明显增大,内部透声差

图2示胆囊周围可见液性暗区分布




图3-图6示胆囊壁局部回声中断,探头加压及松开时CDFI可见红色及蓝色多普勒信号
典型病例 3
(由丁香园注册用户「happyivy」提供)
患者男,58岁,既往有胆囊结石20余年,3天前出现剧烈腹痛,临床给予杜冷丁止痛,现症状略有好转。超声检查所见如下:

图1示胆囊体积稍大,内部透声差,与周围组织界限模糊

图2示胆囊结石





图3-图7示胆囊壁肝床侧似回声中断,邻近肝脏内可见不规则混合回声

图8示腹腔内积液
超声考虑胆囊穿孔并肝脓肿形成,后经手术证实。
典型病例 4
(由丁香园注册用户「哥特复兴5」提供)
患者女,79岁,晚餐后出现脐周疼痛数小时急诊。患者无发热,实验室检查示白细胞14×109/L,临床考虑阑尾炎,行超声检查所见如下:

图1示胆囊充盈差,囊壁明显增厚,胆囊周围可见无回声环绕分布

图2为高频探头所见,示胆囊壁肝床侧回声中断,周围可见无回声分布
超声诊断为胆囊穿孔,后经手术证实。
典型病例 5
(由丁香园注册用户「ouchen2010」提供)
患者女,75岁,右上腹疼痛就诊。查体示右上腹压痛明显,无明显腹膜炎体征。
超声检查发现胆囊内可见沉积物及结石回声,胆囊近底部可见 0.5cm 回声中断,十二指肠亦可见 0.5cm 回声中断,二者间见 5.8×4.4cm 混合性团块。

图1示胆囊饱满,内透声差,可见沉积物回声

图2示胆囊、胃窦及十二指肠之间可见混合回声型团块



图3-图5为胆囊局部放大图像,显示胆囊囊壁局部回声中断,周围可见不规则混合回声团块

图6和7为相应CT表现
术后诊断为慢性结石性胆囊炎,胆囊-十二指肠穿孔并内瘘形成。
鉴别诊断
若超声发现胆囊壁回声中断,则可明确诊断。针对声像图特征并不典型的病例,结合患者病史、症状及体征,超声检查可提示诊断。
胆囊穿孔后可导致胆囊周围混合回声包绕,类似于肿块,且与胆囊关系密切,超声上可误诊为胆囊占位性病变;胆囊穿孔导致的局部肝脓肿也需与肝占位性病变相鉴别;慢性穿孔累及周围肠管时应与肠道肿瘤鉴别。
鉴别诊断时,应充分考虑患者临床病史及症状体征,结合不同病变的声像图特征及其他影像学表现,予以明确。
治疗预后
胆囊穿孔以手术治疗为主,非手术治疗包括补液、抗感染等对症支持治疗。
参考文献
1. 胡颖, 邓云久, 毛骞. 胆囊穿孔的超声诊断及漏诊分析[J]. 中国误诊学杂志, 2005, 5(7):1232-1233.
2.房书芹, 段天昱, 郭苹. 急性胆囊炎并发胆囊穿孔的超声诊断价值[J]. 中国超声诊断杂志, 2004, 5(7):509-510.
3.唐少珊, 黄丽萍, 刘守君,等. 胆囊穿孔的超声表现[J]. 中国超声医学杂志, 2012, 28(2):160-162.
4.蔡明序, 左晓文, 李红瑜,等. 胆囊穿孔的超声诊断漏诊分析[J]. 中国实验诊断学, 2010, 14(1):138-140.
5. 外科学. 第8版. 人民卫生出版社
6. 于德江, 董宝玮, 梁萍,等. 超声诊断胆囊穿孔的临床应用[J]. 中华超声影像学杂志, 2002, 11(7):443-444.
来源:超声时间